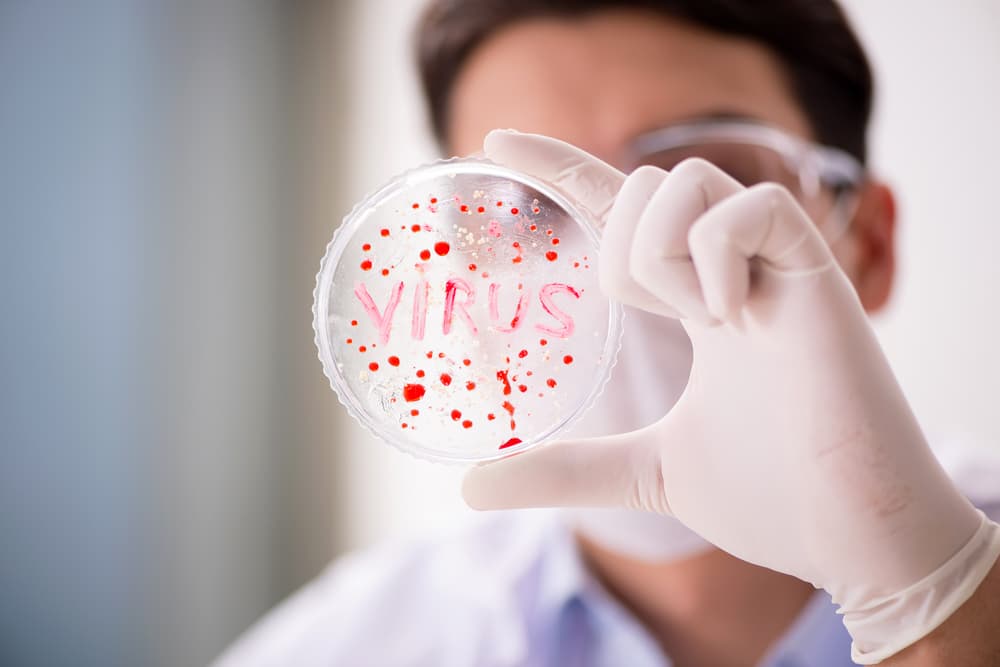

El mundo entero se ha centrado en una sola noticia: la pandemia de coronavirus que está presente en 168 países y que tiene a muchas naciones en estado de cuarentena.
Brasil también desarrolla una vacuna contra el coronavirus, pero con partículas artificiales
Por supuesto, la comunidad científica no se ha quedado con los brazos cruzados. Además de Estados Unidos y China, Brasil está trabajando en el desarrollo de una vacuna contra el COVID-19.

Los esfuerzos por detener el coronavirus
En Estados Unidos se creó una vacuna experimental contra el coronavirus, que ha traído esperanza al mundo.
El ensayo clínico ya comenzó y se suministró una dosis a una mujer de 43 años, llamada Jennifer Haller. Ella está en perfecto estado de salud y se ofreció como voluntaria.
La primera persona en el 🌎, en recibir la prueba de la #vacuna ( mRNA-1273 ) vs el #Covid_19 : Jennifer Haller de 43 años. Otros 44 voluntarios sanos, también la recibieron en Seattle. La foto es de @AsociatedPress pic.twitter.com/81jHVEGiZ2
— Alberto (@almagoch) March 18, 2020
Mientras tanto, en China, la empresa CanSino Biologics y la Academia Militar de Ciencias Médicas también se encuentran trabajando en una vacuna, que ya está lista para ser probada en humanos.

Latinoamérica también ha mostrado avances para combatir el coronavirus. Científicos brasileños de la Facultad de Medicina de la Universidad de São Paulo están en proceso de investigación, para lograr una vacuna que no será fabricada con material genético.

El objetivo de los investigadores es lograr una vacuna hecha a través de partículas artificiales, semejantes al coronavirus; así lo explicó Jorge Kalil, coordinador del proyecto para EFE.
De esta forma, tendrá una estructura muy similar a la que tiene el COVID-19, lo que augura buenos resultados.
La mayoría de los científicos de otros países, como China y Estados Unidos, han desarrollado sus investigaciones haciendo uso del propio material genético del virus, es decir, usan moléculas sintéticas del ácido ribonucleico del COVID-19.

Sin embargo, Kalil sostiene que este método podría no ser del todo efectivo. Es por ese motivo que él y su equipo han decidido seguir otro camino para prevenir más contagios de coronavirus.

Todas estas vacunas aún están en período de prueba, por lo que es casi seguro que, si demuestran funcionar, podrán comenzar a aplicarse a partir del 2021.
No obstante, es muestra de que la ciencia médica ha avanzado mucho en los últimos años.
mini:
Sigue leyendo:










